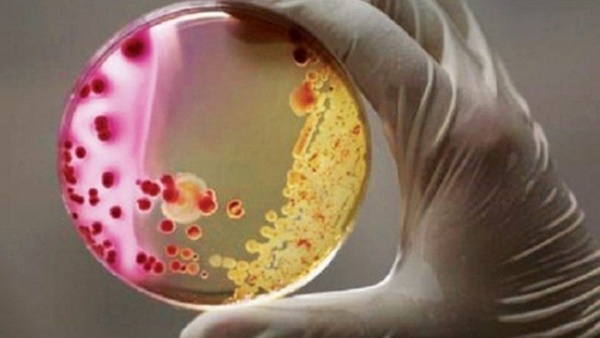
Mikrobiyom haritası: İnsana dair yeni bir kavram ortaya çıktı!

Mikrobiyoloji
Mikrobiyoloji, mikropları ve "mikro" boyutundaki organizmaları inceleyen bilim dalına verilen isimdir. Mikrobiyoloji bakteriler, virüsler, algler vb. canlıların incelenmesini içerir. Mikroorganizma denilince bakteriler, virüsler, protozoonlar, mantarlar ve ilkel algler anlaşılır.